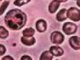

Цветки бузины, лист крапивы двудомной, корень петрушки, кора ивы (всего
поровну). Столовую ложку измельченного сбора заварить стаканом кипятка,
кипятить 5 минут на слабом огне, охладить, процедить. Пить по 2 стакана
отвара в день при артритах различной этиологии.
Вишня обыкновенная (плоды). В народной медицине плоды вишни употребляют
с молоком при воспалениях суставов – артритах.
Звездчатка средняя, мокрица (свежая трава). Столовую ложку травы на 1
стакан кипятка. Настоять, укутав, 4 часа, процедить. Принимать по 1/4
стакана 4 раза в день до еды при артритах, подагре.
Грыжник душистый (свежая трава). 3 чайные ложки свежей травы на 500 мл
кипятка. Настоять, укутав, 1 час, процедить. Принимать по 1/3 стакана
3-4 раза в день холодным или теплым при артритах, ревматизме, подагре.
Портулак огородный (трава). Столовую ложку свежей травы на 1 стакан холодной
воды. Кипятить 10 минут. Настоять, укутав, 2 часа, процедить. Принимать
по 1-2 столовые ложки 3-4 раза в день при артритах.
1.
inetbuket.ru:
"Парад планет" в Большом Планетарии Москвы

09.06.2012
... в физическом и половом развитии детей. Тяжелая инвалидность приводит таких детей к психологической, социальной и профессиональной дезориентации. Наиболее инвалидизирующим является юношеский
артрит. У 50% детей с юношеским
артритом инвалидность развивается в течение первых 10 лет болезни, у 20% детей с поражением глаз развивается ...
4.
www.pravda.ru:
Сотрудники зоопарка усыпили косоглазого опоссума (+фото)

28.09.2011
... самка опоссума, сообщает BaltInfo. Смотрители приняли решение усыпить знаменитого зверька, когда все попытки излечить ее от
артрита и других старческих болезней оказались безуспешными. Как рассказал директор зоопарка Йорг Юнгхольд, непростое решение было принято в интересах животного. ...
6.
www.yoki.ru:
Невероятно толстый кот похудел и лишился рекорда

01.08.2011
... толстопуза у его хозяев, которым очень нравилось баловать своего питомца жирной и обильной пищей, когда поняли, что у Отто начинаются проблемы со здоровьем. Из-за проблем с весом он страдал от
артрита. Врачи посадили невероятно толстого кота-рекордсмена весом более 16 килограммов на строжайшую диету, отмечает портал skuky.net. ...
7.
www.yoki.ru:
Горилле-долгожительнице исполнилось 53 года

23.12.2009
... ей удалось быстро набраться сил и, впоследствии, она отличалась отменным здоровьем среди своих соплеменников. До сих пор горилла находится в хорошей форме, но не так давно у нее был обнаружен
артрит. ...
8.
www.yoki.ru:
Майкл Джексон был совершенно здоров

02.10.2009
... Джексона обнаружили лишь
артрит спины и нескольких пальцев, а также хроническое воспаление легких. Сердце, почки и большинство других органов музыканта функционировали более чем нормально. Судмедэксперты уверяют, что воспаление ...
9.
inetbuket.ru:
Артрит будут лечить клетками крови?

15.08.2008
... Университета Ньюкасла разработали новую методику лечения ревматоидного
артрита. В основе данной методики лежит подавление аутоиммунных реакций модифицированными клетками крови пациента. В ближайшее время будут проведены исследования, в которых примут ...
10.
www.yoki.ru:
В Одессе слону провели уникальную стоматологическую операцию
15.08.2008
... из Одесского зоопарка осуществили уникальную операцию слону. Огромному животному, к тому же больному
артритом, удалили один бивень, пораженный пульпитом.Пациентом был 33-летний индийский слон по имени Тарун. Операция прошла успешно. Как уточнил на пресс-конференции директор Одесского ...
11.
www.yoki.ru:
Серьги и зубные пломбы вызывают спазмы мышц
08.07.2008
... исповедующих такой метод лечения, британский криопрактик Саймон Кинг утверждает, что серьги в основном провоцируют шейные и зубные боли, а украшения вроде цепочек, ожерелий и часов могут вызвать
артрит. ...
12.
www.yoki.ru:
Ученые доказали: при артрите полезен алкоголь. Оценено и курение
06.06.2008
... исследователи выяснили, что алкоголь, как и табак, оказывает влияние на развитие у людей ревматоидного
артрита. При этом, крепкие напитки и сигареты действуют противоположным образом: водка снижает риск возникновения заболевания, а табак - повышает. Ученые также сделали важное ...
13.
inetbuket.ru:
Спиртное оказалось спасением от артрита

05.06.2008
... Швеции группа учёных из Каролинского университета сделала любопытное открытие. Оказывается, потребление алкоголя на 50% снижает риск развития ревматоидного
артрита. За основу своего исследования учёные взяли итоги более раннего исследования 2750 человек, которое было проведено в Швеции и Дании. Люди отвечали на вопросы по поводу своих ...
14.
www.yoki.ru:
Британским собакам необходима диета
06.03.2008
... трети домашних собак в Великобритании страдает от ожирения. По словам экспертов, многие из собак больны диабетом, страдают от
артрита и сердечных заболеваний. Такую информацию обнародовали на крупнейшей в мире и самой авторитетной выставке собак, которая открылась в Бирмингеме. ...
15.
www.yoki.ru:
Женщины с длинными безымянными пальцами приговорены
04.01.2008
... с длинными безымянными пальцами больше других подвержены риску развития
артрита колена. Такое заявление сделали ученые исследователи Ноттингемского университета. Как правило, указательный и безымянный пальцы у женщин одинаковые. Ученые полагают, что женщины, у которых ...